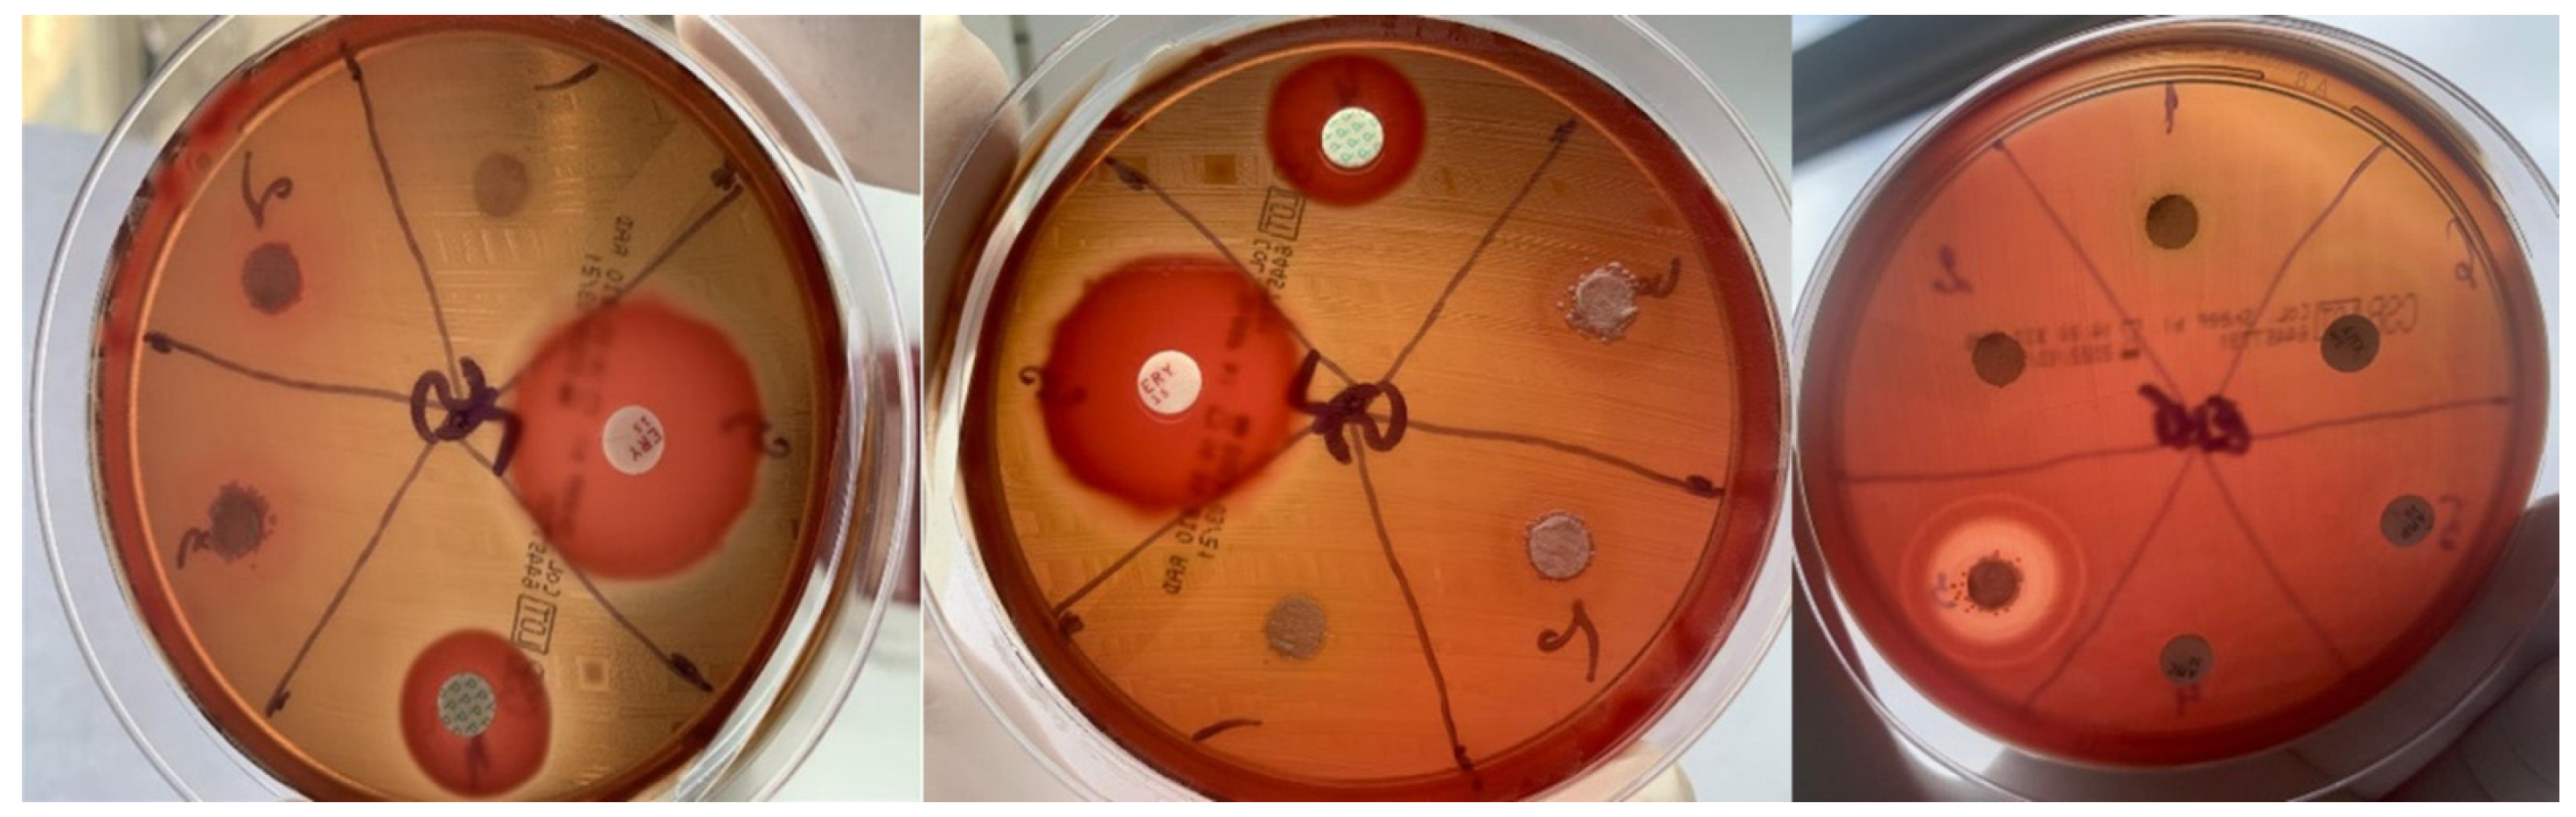
Applsci 13 06830 g004
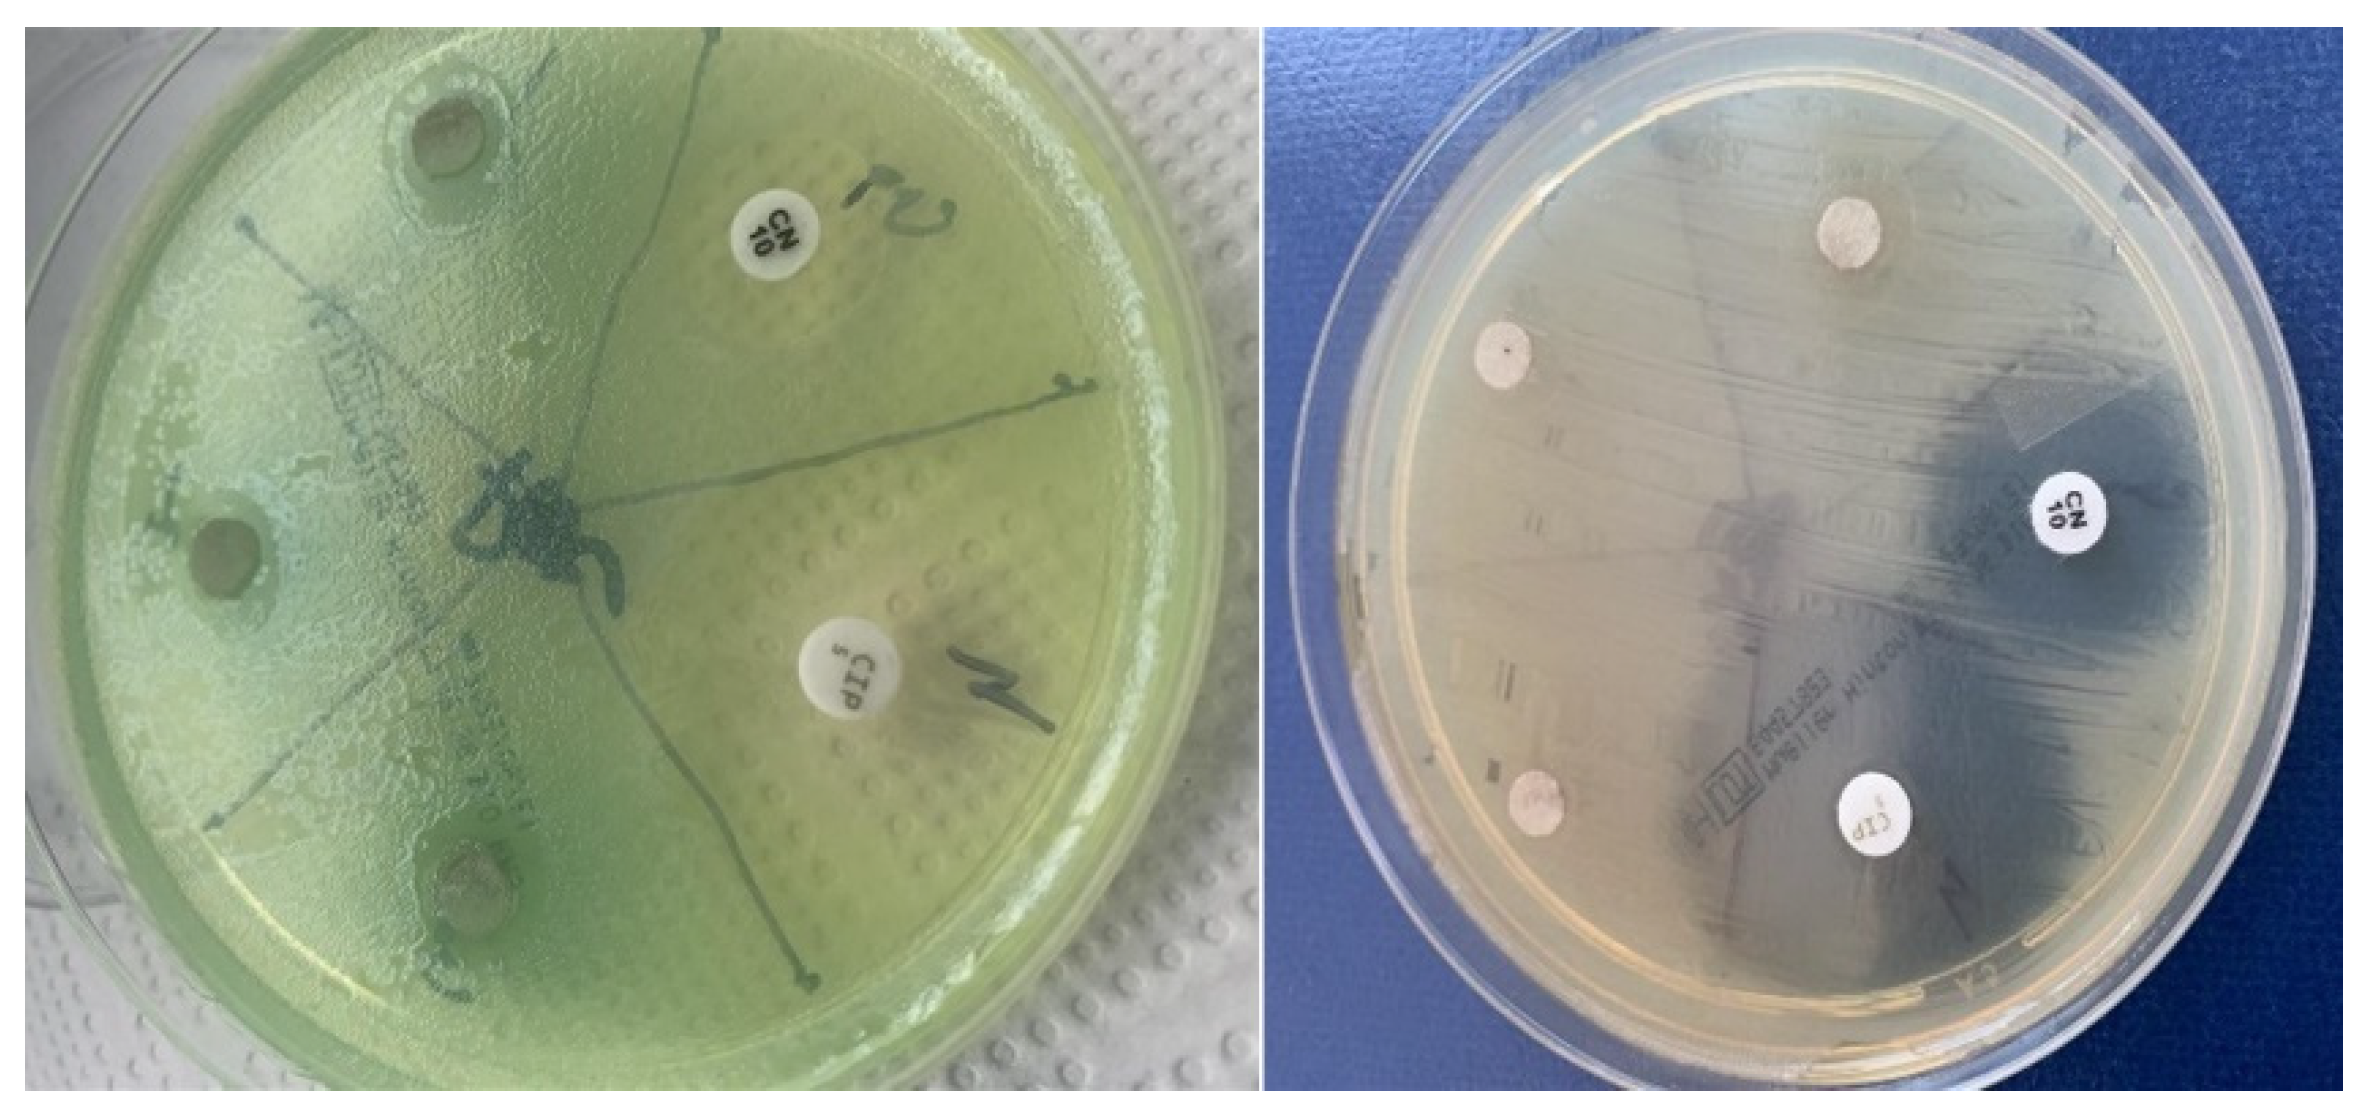
Applsci 13 06830 g006

Abstract
The aim is to evaluate the antibacterial and antifungal properties of the extracts obtained from Lysimachia nummularia L. in order to be able to introduce these extracts into pharmaceutical products and obtain useful products in the infectious and antifungal pathology of the oro-dental cavity. Extracts from different parts of the studied species have been obtained and chemically characterized: the total polyphenols in 40% ethanolic extracts have been determined and the caffeic and chlorogenic acids and trans-resveratrol, bioactive compounds involved in the antimicrobial properties of the studied species, have been identified, separated, and quantitatively determined. The antibacterial and antifungal activities of the extract of Lisymachia nummularia L. were determined using the diffusion method against a set of bacteria isolated from samples from different patients with diseases of the oro-dental cavity. The extract of Lisymachia nummularia L. exhibited antimicrobial activity against Gram-positive bacteria more than Gram-negative, where the effect was weaker; however, it had no antifungal effects on Candida albicans. Another aspect that must be emphasized is that the best antibacterial results were obtained from the aerial segment of the plant, the part where the highest concentration of polyphenols was identified in the studies presented. These results indicate that the pharmacological effects of the studied bacterial species support the use of extracts in obtaining pharmaceutical products that can be used to optimize treatment schemes in oro-dental diseases.
1. Introduction
There are many biologically active compounds from plant extracts that have been shown to have antibacterial properties and can potentially help in developing resistance against bacterial infections. These natural plant extracts can potentially be used in combination with conventional antibiotics to enhance their effectiveness or as an alternative to antibiotics to reduce the risk of antibiotic resistance.
However, it is important to note that more research is needed to fully understand the antimicrobial properties and potential uses of these compounds from natural plant extracts. It is also important to consult with a healthcare professional before using any natural plant extracts as a treatment. They may be incorporated into oral health products, such as mouthwash, toothpaste, biofilms, and tooth powder, as they have been shown to have beneficial effects on oral health [1]. They can reach their goal and purpose in relation to the targeted organs [2,3,4].
Lysimachia nummularia L. has a long history of use in traditional folk medicine. In traditional Chinese medicine, it has been used to treat various ailments, such as inflammation, diarrhea, and jaundice. It has also been used to promote diuresis, in detoxification, and to alleviate pain [5]. In European traditional medicine, the plant has been used as an astringent, diuretic, and expectorant. It has also been used to treat jaundice, kidney stones, and bladder infections. Additionally, it has been used as a topical remedy for skin conditions, such as eczema, psoriasis, and dermatitis [6]. In Native American traditional medicine, Lysimachia nummularia L. was used to treat digestive disorders, respiratory infections, and skin ailments [7].
Lysimachia nummularia L. contains various chemical compounds, including flavonoids, iridoids, triterpenoids, and tannins. Some of the specific compounds found in this plant include hyperoside, a flavonoid with antioxidant properties that has been shown to have anti-inflammatory and neuroprotective effects, rutin, another flavonoid with antioxidant properties that has been found to have anti-inflammatory and antitumor effects [8,9], nummularoside and ursolic acid, triterpenoids with anti-inflammatory, antitumor, and antiviral activities [10], and tannins, a compound with astringent properties that can be used to treat diarrhea, hemorrhoids, and other gastrointestinal disorders [6]. These compounds are believed to contribute to the medicinal properties of Lysimachia nummularia L., although further research is needed to fully understand their effects and potential use in medicine.
Before obtaining the dried extracts, we previously identified, separated, and quantitatively determined the phenolic compounds obtained from Lisymachia nummularia L. (radix, herba, and flores) and thus we demonstrated its antioxidant properties [11].
The human oro-dental cavity hosts over 700 bacterial species (Gram-positive, Gram-negative) and is defined as one of the most complex microbial flora in the human body; most of these bacterial species are associated with dental plaque and may represent important elements in the etiopathogenesis of periodontitis and dental caries [12]. These diseases were identified in recent reports by the WHO as being the most common infectious human diseases that constantly register an increase in incidence in all countries of the world.
Trans-resveratrol is a natural phenolic compound found in various plants, including grapes and peanuts, and has been studied for its potential antibacterial effects against Enterococcus faecalis, as well as its ability to induce the production of plant defense compounds, such as phytoalexins [13].
Some studies suggest that trans-resveratrol may have antimicrobial effects against a range of microorganisms, including bacteria, viruses, and fungi, and that it was effective in inhibiting the growth of several Enterococcus species, including Enterococcus faecalis and Enterococcus faecium. The researchers also noted that resveratrol was able to disrupt the biofilm formation of these bacteria, which is a key factor in their ability to cause infections [14].
Trans-resveratrol also has anti-inflammatory properties, which may help reduce inflammation in the gums and prevent the progression of periodontal disease. In addition, it has been shown to reduce oxidative stress and protect against damage to the oral tissues [15].
The interest related to the antibacterial effects of the secondary metabolites of plants and the expectations regarding the possibility of optimizing treatment schemes in oro-dental diseases are very high, taking into account some known disadvantages of antibiotics (side and adverse effects). The purpose of the study is to demonstrate the antibacterial and antifungal properties of the extracts obtained from Lysimachia nummularia L.
2. Materials and Methods
2.1. Plant Material
Amounts of 10 g of each component part of the plant were pulverized through a 315 μm sieve (Lysimachiae herba, Lysimachiae radix, and Lysimachiae flores) and were extracted by maceration with 100 mL of ethanol 40% (v/v) for 14 days. The solutions were kept at room temperature and in the dark during the maceration. The extracts were stirred using a magnetic stirrer at 2000 rpm. The extractive solutions obtained were brought to the residue with the help of a TURBOVAP rotary evaporator at 40 °C.
The extracts were filtered through 0.45 μm membrane filter (Teknokroma, Barcelona, Spain, CEE).
2.2. Characterisation and Standardization of the Extracts
To assess the quality of the dried extracts and to capitalize on them therapeutically in the form of oro-dental preparations, it is aimed to establish the organoleptic properties and the water content and to standardize the determination of the content in active principles, according to the current edition of European Pharmacopoeia (EP 10.0) [16].
2.2.1. Determination of Organoleptic Characteristics
The appearance and color of the extract were determined, by analyzing it with the naked eye. The taste was investigated by maintaining a small amount of extract in the mouth, after which it was discarded and the mouth was rinsed several times with water. The smell was investigated by breathing in the air above a quantity of extract displayed in a vessel with a large area.
The determination of the consistency was assessed according to the types of extracts described by EP 10.0 (fluids, soft, or dried) by the amounts of volatile substances per 100 °C [16].
The determination of solubility usually refers to the solubility of the extract in the solvent used in the preparation.
The loss on drying was determined per 1 g of dry extract by keeping the oven at 105 °C for approximately 3 h, for bringing it to a constant mass, and reported per 100 g extract.
The dried extracts were preserved in brown containers, of small capacity, well closed, away from light, at temperatures of 8–15 °C.
2.2.2. Preliminary Research on the Standardization of Extracts
In order to standardize some dry extracts, we considered that the determination of the content of total polyphenols and caffeic and chlorogenic acids as well as the determination of trans-resveratrol in Lysimachiae herba and Lysimachiae radix would be representative for the pharmacodynamic action.
2.3. Determination of Content in Active Principles
The therapeutic action of the extract being printed by polyphenols, we considered as representative the determination of total polyphenols (photocolorimetric and by HPLC).
2.3.1. Total Polyphenol Content
We determined the total polyphenols in dried extracts obtained from Lysimachiae herba, Lysimachiae radix, and Lysimachiae flores using the spectrophotometric method with some modifications [11].
Polyphenols contained in plant extracts react with the Folin–Ciocalteu reagent. A blue chromophore composed of a phosphotungstic–phosphomolybdenum complex is obtained from the reaction. The maximum absorption of the chromophores depends on the concentration of phenolic compounds and the alkaline solution.
To obtain the solutions to be analyzed, the extracts were dissolved in 100 mL of 40% ethanol and were filtered.
To the 0.5 mL solution obtained, 1 mL of Folin-Ciocâlteu reagent diluted 1:1 and 25 mL of water were added.
2.3.2. Chromatographic Analyses
All the chromatographic analyses were carried out using HPLC-UV. The analytical method was developed using a reverse-phase Zorbax Eclipse XDB-C18 column (4.6 × 150 mm, 5 µm) using a gradient program with two solvent systems. The mobile phase consisted of water (0.1% acetic acid) as solvent A and acetonitrile as solvent B.
Separations were performed by a gradient elution as follows: 0–5 min, 95–90% A; 5–7.5 min, 90–80% A; 7.5–10 min, 80% A; 10–12 min, 80–95% A; and 12–13 min, 95% A. The mobile-phase flow rate was 1mL/min; the injection volume was 10 µL. The chromatographic runs were carried out at 30 °C. UV detection was performed at 310 nm [11,17].
2.4. Pathological Products Analyzed
The pathological products used in this study were collected from patients with dental caries and periodontitis, endodontic infections, and acute pharyngo-tonsillitis, after a previous oro-dental clinical examination.
The patients included in this study were informed, with their written consent in this regard, as well as the consent of the Department of Research and Innovation, the Bio-Ethical Commission of the Ovidius University of Constanta with UOC registration number no. 15162/11 May 2021.
The samples taken according to standard methods were: dentin taken from softened dentin of dental caries, periodontal pus, product from post-extraction alveolitis, product from root canals, and pharyngeal exudate.
2.5. Selected Microorganism
We tested the extracts obtained from Lysimachia nummularia L. on freeze-dried, stabilized, and viable American Type of Culture Collection (ATCC) bacterial and fungal reference strains.
The choice of reference strains was made from a varied range of bacteria and fungi, but we took into account that there are differences regarding the covering structures of bacteria and fungi and also that there are differences regarding the chemical components of the bacterial wall in Gram-positive bacteria, compared with Gram-negative ones; for these reasons, representatives from all these groups are included in the list of species.
The antimicrobial properties of plant extracts were tested against the following Gram-positive bacteria: Streptococcus pyogenes ATCC 19615, Streptococcus pneumoniae ATCC 46619, Enterococcus sp. ATCC 23212, and Staphylococcus aureus ATCC 29213. They were tested against the following Gram-negative bacteria: Escherichia coli ATCC 25922, Klebsiella pneumoniae ATCC 13883, and Pseudomonas aeruginosa ATCC 27853 as well as one pathogenic fungus Candida albicans ATCC 10231. All were purchased from the American Type Culture Collection (ATTC).
2.6. Determination of Bacterial Species Isolated from Pathological Products Taken in the Study
The pathological products were seeded on blood agar medium, and the bacterial species were identified using the Api-ident system. The Api-ident system is a standardized system based on the evaluation of 20 biochemical tests that allow the identification of most species of streptococci, enterococci, and anaerobic or facultatively anaerobic bacterial species, which are of particular interest in the pathology of the oro-dental cavity [18,19].
After Gram staining, a series of biochemical tests known as API (Analytical Profile Index, BioMérieux®, Lyon, France) were carried out. Gram-negative bacteria were identified using API Strip 20 E (Analytical Profile Index, BioMérieux®, Lyon, France).
As a principle, API 20 strips consist of 20 microtubes containing dehydrated culture media for the identification of types of enzymatic activities or the fermentation of sugars. The strips are inoculated with a bacterial suspension of a pure culture, the density of which is controlled according to the working protocol, which is distributed evenly in the 20 spaces of the strips.
During the 24 h thermostat at 37 °C, as a result of the metabolic processes specific to each bacterial species, there will be color changes visible to the naked eye or revealed after the addition of some reagents. Reactions are interpreted according to the analytical profile provided by each identification kit.
2.7. Testing the Bacterial Sensitivity to the Extracts Taken in the Study Compared to the Antibiotics
An antibiogram is a laboratory qualitative test that determines the sensitivity of a bacterial isolate to different antibiotics and chemotherapeutics. It involves growing a sample of the bacteria on a culture plate and then exposing the bacteria to various antibiotics and chemotherapeutics. The growth of the bacteria is then observed to determine which antibiotics are effective in inhibiting or killing the bacteria [20,21].
To test the sensitivity of bacteria to antibiotics, the diffusimetric method is used, which is a qualitative method.
The principle of the method aims at seeding a bacterial suspension to be tested on the surface of a gelatinous culture medium, followed by the subsequent deposition of microcompresses with different antibiotics or chemotherapeutics. Antibacterial substances diffuse into the culture medium, showing a constant decrease in the concentration gradient from the edge of the antibiotic disk to the periphery. After a 24 h incubation at 37 °C, the interpretation is made, which consists of measuring the zone of inhibition, in which the bacteria did not develop, the dimensions of this zone being directly proportional to the sensitivity of the bacteria to the respective antibiotic.
Given the fact that in the present study we wanted to assess the level of sensitivity of some bacterial strains to the obtained extracts, we adapted the diffusimetric method, using the same principle but replacing the antibiotic tablets with sterile filter paper rounds, with the same diameter as of the antibiotic tablets, impregnated in the test solution; we quantified the volume of saturating solution and found that the filter paper washer is saturated with 10 µL.
The interpretation of results is performed by measuring the diameter of the zone of inhibition of the development of bacterial colonies around the filter paper washers, expressed in mm.
If the medium is transparent, the reading is performed directly on the bottom of the plate, in reflected light, and if the media of the plates is agar-blood, the diameter measurement is made on the surface of the medium.
The expression of the results is conducted by relating the size of the zone of inhibition to the standards of critical diameters for different antibiotics, which allows the definition of strains as sensitive, intermediate, and resistant [22,23,24]. The bacteria that we had the right to test were grown on various culture media; as a positive control, antibiotics and antifungals were used, and as a negative control, distilled water was used (Table 1).
Table 1.
Bacterial species and antibiotics/chemotherapy used.
The plates were incubated for 24 h at 37 °C, after which the results were read by measuring the zones of inhibition in millimeters for each reference bacterial species; three readings were taken, and the mean and standard deviation (SD) were obtained.
2.8. Statistical Analysis
Continuous data are presented as mean ± SD of at least three independent experiments (n = 3). One-way analysis of variance (ANOVA) followed by Tukey post hoc tests were performed to determine statistical differences between variables using GraphPad Software 9, Inc., San Diego, CA, USA.
3. Results
After evaporation to the TURBOVAP from 100 g of plant product, dried extracts were obtained in the quantities and with the organoleptic characteristics mentioned in Table 2.
Table 2.
Obtained extracts from plant parts Lysimachiae herba, Lysimachiae radix, and Lysimachiae flores in 40% ethanol.
The smallest amount of extract was obtained from the plant product Lysimachiae flores. Close amounts of the extracts were obtained from Lysimachiae radix and Lysimachia herba (Table 2).
The dried extracts obtained are almost completely soluble in the solvents used to obtain them.The loss on drying (2.7602–2.8243%) falls within the limits prescribed by EP 10.0 for dried extracts, of not more than 5%. According to this classification, in the extracts category, the consistency of the preparations is dried.
The results of the total polyphenol content are presented in Figure 1.
Figure 1.
Comparative data of the content of total polyphenols obtained by the maceration extraction methods for Lysimachiae herba, radix, and flores extracts, with ethanol 40% (v/v). Results are indicated as mean ± SD of data (n = 3). Asterisks indicate statistical significance examined by ANOVA with Tukey post hoc test for multiple comparison among the extracts (*** p < 0.001).
The highest amount of total polyphenols content was determined in Lysimachiae radix. Comparing the HPLC chromatograms of the standards with the chromatograms of the samples (Figure 2 and Figure 3), it was possible to identify and quantify the compounds mentioned.
Figure 2.
Comparative data of the content of chlorogenic and caffeic acids and trans-resveratrol identified in Lysimachia herba (I), radix (II), and flores (III) extracts, with ethanol 40% (v/v). Results are indicated as mean ± SD of data (n = 3). Asterisks indicate statistical significance examined by ANOVA with Tukey post hoc test for multiple comparison among the extracts (significant: * p < 0.05, ** p < 0.01, *** p < 0.001.
Figure 3.
HPLC-DAD chromatograms at 310 nm: green line corresponds to the ethanolic solution of Lysimachiae herba samples with standard solution; red line corresponds to the standard solution.
The results obtained for the testing of the extracts obtained from all the component parts of the Lysimachia nummularia L. species on lyophilized, stabilized, and viable bacterial and fungal strains of the ATCC reference are presented in Table 3, together with the bacterial species and the antibiotics/antimycotics used for the comparative testing against the extracts obtained.
Table 3.
Evaluation of the antibacterial sensitivity of Lysimachia nummularia L. extracts on reference strains.
We tested the antibacterial activity of the dried extract obtained from Lysimachia nummularia L. (herba, flores, and radix) on the bacterial and fungal strains identified from the pathological products examined, compared to the usual antibiotics and antifungals used in the conditions from which the pathological products under study were generated (Figure 4, Figure 5 and Figure 6).
Figure 4.
Inhibition areas of the extracts obtained from Lisymachia nummularia L. compared to antibiotics, for Streptococcus, Pneumococcus, and Enterococcus faecalis.
Figure 5.
Inhibition areas of the extracts obtained from Lisymachia nummularia L. compared to antibiotics for Stafilococcus aureus and Klebsiella pneumoniae.
Figure 6.
Inhibition areas of the extracts obtained from Lisymachia nummularia L. compared to antibiotics for Pseudomonas and Escherichia coli.
The results of this bacteriological study were from tests on a group of five bacterial strains selected from both Gram-positive and Gram-negative bacterial species, strains isolated from pathological products taken from patients with various dental conditions.
Given the fact that the strain of Candida albicans proved to be totally resistant to all three types of extracts, this strain was later excluded, so the study was carried out only on the two types of bacteria according to the classification of Christian Gram.
The results were expressed using the indicators S—sensitive, I—intermediate, and R—resistant to antibiotics specific to each bacterial strain used in the test.
The results regarding the evaluation of the sensitivity of the selected bacterial strains to the extracts obtained from Lysimachia nummularia L. are presented in Table 4.
Table 4.
Evaluation of the antibacterial sensitivity of Lysimachia nummularia L. extracts on strains isolated from pathological products from the oral cavity.
The relevant results were obtained in the case of the study of the antimicrobial activity of dried extracts obtained from Lysimachia radix on E. Faecalis, which is a specific Gram-positive bacterium found especially in endodotic infections. The results obtained indicate an inhibitory activity of the extract of Lysimachia radix on E. faecalis, while the positive control with ampicillin showed a sensitivity to antibiotics of at least 17 mm, while the resistance is defined for a diameter of 16 mm or less according to the standards.
4. Discussion
The expansive use of antibiotics has had as its reverse the emergence of the phenomenon of bacterial resistance and thus many antibiotics to many of these products used in medical therapeutic practice were excluded [25,26].
Thus, it has become a challenge for researchers around the world to find new ways in which these simple-structured organisms can be destroyed. It is estimated that there are around 500,000 species of plants that live in different areas of the earth; they represent immeasurable sources of secondary metabolites, so that the plant world can be considered the most important source of biologically active compounds [27,28].
Lysimachia nummularia L., a plant present in the national botanical area, aligns with this trend to study the antibacterial properties of plant extracts [7,29].
This pillar of research was supported by the results presented in the previous chapter in which we demonstrated that active metabolites are presents in the ethanolic dried extracts 40% in variable concentrations.
After these determinations with indicative potential, we were able to establish an optimal extraction method to obtain extracts with possible antimicrobial properties.
Due to the fact that the dry extract of Lysimachia radix contains higher levels of certain compounds compared to the dried extracts of Lysimachia herba or Lysimachia flores, these extracts can have an effect in the prevention and treatment of oro-dental infections produced by Gram-negative bacteria.
The results obtained after the identification, separation, and quantitative determination of chlorogenic and caffeic acids and trans-resveratrol prove that the largest quantity was obtained at the level of Lysimachia radix, so we can standardize this dry extract in these separate polyphenolic compounds.
The obtained extracts were standardized in active principles with antimicrobial potential, choosing from the previously determined phenolic acids: trans-resveratrol and caffeic and chlorogenic acids.
Moreover, the determination of total polyphenols was a parameter chosen in the standardization of the obtained extracts [11].
Phenolic compounds represent a group of secondary metabolites with important pharmacological properties for all medical fields. The explanation of the effects obtained by the extracts studied on reference bacterial strains and isolated from pathological products is related to antibacterial mechanisms produced by the targeted secondary metabolites, which are cited in the specialized literature, as follows [30].
Caffeic acid, present in the highest concentration in the aerial part of the plant, has an important antibacterial effect through metabolic disturbances related to dysfunctions of the bacterial respiratory processes, followed by the acidification of the intracytoplasmic pH and death [25,31]. When consumed, it is metabolized in the body into several metabolites, including caffeic, ferulic, and quinic acids [32].
Caffeic acid has been studied for its potential antibacterial effects. Some studies suggest that caffeic acid may have antibacterial activity against a range of bacteria, including both Gram-positive and Gram-negative species. For example, one study found that caffeic acid was effective against Staphylococcus aureus, a common cause of bacterial infections [33].
Caffeic acid has been studied for its potential effects on oral health and has shown promising results in preventing and treating oral diseases [32].
Several studies have found that caffeic acid can inhibit the growth of oral pathogens, such as Streptococcus mutans and Porphyromonas gingivalis, which are associated with dental caries and periodontitis, respectively. Caffeic acid works by disrupting the bacterial cell membrane and inhibiting the activity of enzymes involved in bacterial metabolism [34].
Chlorogenic acid, identified in the highest concentration in the 40% alcoholic extract of the plant’s roots, has important antibacterial properties achieved by seriously disrupting bacterial metabolism by affecting the bacterial wall and the permeability of the cytoplasmic membrane, as well as by neutralizing the pathogenicity factors of some bacteria [35].
Chlorogenic acid has also been found to have antibacterial effects against several oral pathogens, including Streptococcus mutans, which is a major contributor to dental caries. It works by disrupting the bacterial cell membrane and inhibiting bacterial metabolism [36].
The phenolic acids have antioxidant properties and anti-inflammatory effects, making them potentially useful compounds for the prevention and treatment of various diseases. Overall, the potential benefits of these acids for oral health are promising, and further research is needed to fully understand the extent of these benefits. However, incorporating these extracts in dental products may be a beneficial strategy for promoting oral health [37].
Trans-resveratrol, a well-known phenolic compound, has antibacterial effects against E. faecalis by disrupting the bacterial cell membrane and inhibiting bacterial metabolism, resulting in cell death. Other phenolic compounds, such as caffeic acid and chlorogenic acid, also exhibit antibacterial effects against E. faecalis. The presence of trans-resveratrol, a phytoalexin found in plants sensitive to oxidative processes, can contribute to inhibitory activity. Trans-resveratrol stimulates the production of phytoalexin in various plants, including grapes, suggesting that this is one of its mechanisms for strengthening plant defenses. Additionally, trans-resveratrol displays antibacterial effects against E. faecalis in both planktonic cells and biofilms [13,38,39,40,41].
The results obtained in Table 3 and Table 4 indicate that the extracts obtained from Lysimachia nummularia L. show antibacterial activity against bacterial species isolated from oro-dental diseases and reference strains.
Dried extracts obtained from Lysimachia nummularia L. (herba, flores, and radix) showed zones of inhibition against the Gram-positive bacterium S. mitis, with average diameters of 6 ± 0.02 mm for all three extracts. However, the extracts did not show a significant inhibition against the Gram-positive bacterium S. aureus, since the average diameter of inhibition remained at 8 ± 0.01 mm, indicating resistance to the extracts. Positive control antibiotics, such as penicillin and gentamicin, showed the expected inhibitory effect on bacterial strains.
It is observed that the extracts obtained from Lysimachia have a significant inhibitory effect against the Gram-positive bacterium E. faecalis with an average inhibition diameter of 8 mm by Lysimchia herba and flores and an average inhibition diameter of 17 mm produced by Lysimachia radix. From the results with the positive control, we can see that the dry extracts of Lysimachia nummularia L. showed comparable effects; For example, the extract obtained from Lysimachia radix shows an inhibition of 17 mm for E. faecalis, while the antibiotic had a diameter of at least 17 mm, which indicates the sensitivity of the bacterium to ampicillin.
The dried extracts from Lysimachia nummularia L. did not show significant inhibition against these Gram-negative bacterial strains of E. coli and P. aeruginosa because the average diameter of inhibition was similar to the negative control (distilled water) for both bacterial strains (5 mm). Gentamicin, a commonly used antibiotic, exhibited the expected inhibitory effect on the Gram-negative bacteria E. coli and P. aeruginosa.
Lysimachia radix extract shows inhibitory activity on the Gram-positive bacterium E. faecalis, and this can be a promising source in terms of the potential for use of the extract in combating this bacterium in endodontic infections.
E. faecalis is known to be a major cause of persistent and recurrent endodontic infections, which are infections that occur inside the tooth, particularly after root canal treatment. E. faecalis can form biofilms on tooth surfaces, making it difficult to eradicate with conventional treatment methods [42,43].
Moreover, E. faecalis has been associated with the development of periodontitis, a chronic inflammatory disease that affects the gums and bones that support the teeth. E. faecalis can colonize the periodontal pockets and contribute to the destruction of the periodontal tissues [42,44].
The prevention and treatment of E. faecalis-associated oral infections typically involves the use of antibiotics and/or antiseptics, as well as root canal retreatment and periodontal therapy. However, the emergence of antibiotic-resistant strains of E. faecalis highlights the need for alternative treatment strategies [42].
These may justify the combined use of antibiotics with extracts containing herbal active principles with antibacterial potential.
Some natural compounds, such as phenolic compounds, have shown potential antibacterial effects against E. faecalis and may be useful in the development of new oral care products or as an adjunct therapy for the treatment of oral infections. However, more research is needed to fully understand the potential of these compounds and determine the optimal dose and mode of administration (Scheme 1).
Scheme 1.
Antibacterial action of phenolic compounds on Enteroccocus faecalis in the oral cavity.
The antimicrobial potential of the extract obtained from the roots of the species Lysimachia nummularia L. on Enterococcus faecalis can thus be correlated with the presence of phenolic compounds in the highest quantity and also with the presence of trans-resveratrol and caffeic and chlorogenic acids. The null effect of the extract on Candida albicans may have the following causes: an insufficient concentration of active compounds in the extract, reduced sensitivity of Candida albicans to these compounds, interactions with other substances present in the environment, or specific resistance mechanisms of Candida albicans. It is important to emphasize that Candida albicans can develop resistance to antifungal substances and that this aspect can influence the results observed in our study.
The differences regarding the antimicrobial potential of the extracts obtained from different parts of the plant probably come from the fact that the extracts contain active principles in different quantities and can be explained by the variation in the amount of trans-resveratrol or its absence in the extract obtained from flowers.
5. Conclusions
The results obtained in the present study show that the studied extracts had a stronger antibacterial effect on Gram-positive bacteria, compared to Gram-negative ones, where the effect was weaker; however, they had no antifungal effects.
In the specialized literature accessed, we did not find any data regarding the antibacterial activity similar to those in the present study, but similar results were obtained by Yldirim and colleagues on another species of the genus, Lysimachia vulgaris [45].
Contrary to their results, in which antibacterial effects are presented on the group of Gram-positive cocci, in this study we identified that the studied extracts also have an effect on Gram-negative bacteria species; what should be emphasized is the fact that they also have an effect on bacterial species with established pathogenicity potential, such as Pseudomonas aeruginosa.
Moreover, among Gram-positive cocci species, the studied extracts also had an effect on species with high pathogenicity potential, such as those of the Enterococcus genus.
The good antibacterial results recorded for some bacterial species from the extracts obtained from the other parts of the plant are probably due to the fact that they contain other secondary metabolites that we could not identify.
While the antibacterial effects of phenolic compounds against E. faecalis are promising, more research is needed to fully understand their potential therapeutic applications and determine the optimal dose and mode of administration.
In summary, the potential benefits of trans-resveratrol in the prevention and treatment of E. faecalis associated with oral infections are promising. However, further research is needed to fully understand its effects and to identify the optimal dosage and the method of administration for the dosage form that needs to be obtained. Trans-resveratrol shows potential as a natural compound for the development of new oral care products and as an adjunct therapy for endodontics infections.
Our results indicate that the pharmacological effects of the studied bacterial species support the use of extracts in obtaining pharmaceutical products that can be used to optimize treatment schemes in oro-dental diseases.
Author Contributions
Conceptualization, F.S. and A.P.; methodology, V.B. and F.C.B.; software, A.C.R. and E.C.L.; investigation, F.S., F.N.R. and F.C.B.; resources, I.S.; curation date, D.-E.D. and E.C.L.; writing—original draft preparation, F.S., A.P., E.C.L. and I.S.; writing—review and editing, F.N.R. and E.C.L.; visualization, A.C.R.; supervision, V.B. and A.C.R.; project administration, F.S., A.P. and I.S.; funding acquisition, V.B. and F.C.B. All authors have read and agreed to the published version of the manuscript.
Funding
This research received no external funding.
Institutional Review Board Statement
Not applicable.
Informed Consent Statement
Not applicable.
Data Availability Statement
Not applicable.
Acknowledgments
This work is supported by the project PROINVENT in the framework of the Human Resources Development Operational program 2014–2020, financed from the European Social Fund under the contract number 62487/6 March 2022 POCU 993/6/13/—SMIS Code: 153299 of Romania.
Conflicts of Interest
The authors declare no conflict of interest.
References
- Ciavoi, G.; Dobjanschi, L.; Jurca, T.; Osser, G.; Scrobota, I.; Pallag, A.; Muresan, M.E.; Vicas, L.G.; Marian, E.; Bechir, F.; et al. Comparative Effectiveness of a Commercial Mouthwash and an Herbal Infusion in Oral Health Care. Appl. Sci. 2021, 11, 3008. [Google Scholar] [CrossRef]
- Lugo-Flores, M.A.; Quintero-Cabello, K.P.; Palafox-Rivera, P.; Silva-Espinoza, B.A.; Cruz-Valenzuela, M.R.; Ortega-Ramirez, L.A.; Gonzalez-Aguilar, G.A.; Ayala-Zavala, J.F. Plant-Derived Substances with Antibacterial, Antioxidant, and Flavoring Potential to Formulate Oral Health Care Products. Biomedicines 2021, 9, 1669. [Google Scholar] [CrossRef] [PubMed]
- Saliasi, I.; Llodra, J.C.; Bravo, M.; Tramini, P.; Dussart, C.; Viennot, S.; Carrouel, F. Effect of a Toothpaste/Mouthwash Containing Carica papaya Leaf Extract on Interdental Gingival Bleeding: A Randomized Controlled Trial. Int. J. Environ. Res. Public Health 2018, 15, 2660. [Google Scholar] [CrossRef] [PubMed]
- Braga, A.S.; Abdelbary, M.M.H.; Kim, R.R.; Melo, F.P.d.S.R.d.; Saldanha, L.L.; Dokkedal, A.L.; Conrads, G.; Esteves-Oliveira, M.; Magalhães, A.C. The Effect of Toothpastes Containing Natural Extracts on Bacterial Species of a Microcosm Biofilm and on Enamel Caries Development. Antibiotics 2022, 11, 414. [Google Scholar] [CrossRef] [PubMed]
- Liu, S.; Luorong, Q.; Hu, K.; Cao, W.; Tao, W.; Liu, H.; Zhang, D. Aqueous Extract of Lysimachia christinae Hance Prevents Cholesterol Gallstone in Mice by Affecting the Intestinal Microflora. J. Microbiol. Biotechnol. 2021, 31, 1272–1280. [Google Scholar] [CrossRef]
- Toth, A.; Riethmuller, E.; Alberti, A.; Vegh, K.; Kery, A. Comparative phytochemical screening of phenoloids in Lysimachia Species. Eur. Chem. Bull. 2012, 1, 27–30. [Google Scholar] [CrossRef]
- Bowles, D. Lysimachia nummularia (Primulaceae): A non-native plant in Ozark springs. Missouriensis 2017, 34, 27–33. [Google Scholar]
- Hanganu, D.; Olah, N.K.; Mocan, A.; Vlase, L.; Benedec, D.; Raita, O.; Toma, C.C. Comparative polyphenolic content and antioxidant activities of two Romanian Lysimachia species. Stud. Rev. Chim. 2016, 67, 227–231. [Google Scholar]
- Pandey, P.; Khan, F.; Qari, H.A.; Oves, M. Rutin (Bioflavonoid) as Cell Signaling Pathway Modulator: Prospects in Treatment and Chemoprevention. Pharmaceuticals 2021, 14, 1069. [Google Scholar] [CrossRef]
- Podolak, I.; Koczurkiewicz, P.; Michalik, M.; Galanty, A.; Zajdel, P.; Janeczko, Z. A new cytotoxic triterpene saponin from Lysimachia nummularia L. Carbohydr. Res. 2013, 375, 16–20. [Google Scholar] [CrossRef] [PubMed]
- Suciu, F.; Stoicescu, I.; Lupu, E.C.; Musuc, A.M.; Popescu, A.; Mititelu, M.; Rosca, A.C.; Dumitrescu, D.E.; Badea, F.C.; Caraiane, A.; et al. HPLC Analysis of Polyphenolic Compounds in Lysimachia nummularia L. and Comparative Determination of Antioxidant Capacity. Appl. Sci. 2023, 13, 2159. [Google Scholar] [CrossRef]
- Deo, P.N.; Deshmukh, R. Oral microbiome: Unveiling the fundamentals. J. Oral Maxillofac. Pathol. 2019, 23, 122–128. [Google Scholar] [CrossRef] [PubMed]
- Jadimurthy, R.; Jagadish, S.; Nayak, S.C.; Kumar, S.; Mohan, C.D.; Rangappa, K.S. Phytochemicals as Invaluable Sources of Potent Antimicrobial Agents to Combat Antibiotic Resistance. Life 2023, 13, 948. [Google Scholar] [CrossRef] [PubMed]
- Kharouf, N.; Sauro, S.; Hardan, L.; Fawzi, A.; Suhanda, I.E.; Zghal, J.; Mancino, D. Impacts of Resveratrol and Pyrogallol on Physicochemical, Mechanical and Biological Properties of Epoxy-Resin Sealers. Bioengineering 2022, 9, 85. [Google Scholar] [CrossRef]
- Migliaccio, A.; Stabile, M.; Bagattini, M.; Triassi, M.; Berisio, R.; De Gregorio, E.; Zarrilli, R. Resveratrol Reverts Tolerance and Restores Susceptibility to Chlorhexidine and Benzalkonium in Gram-Negative Bacteria, Gram-Positive Bacteria and Yeasts. Antibiotics 2022, 11, 961. [Google Scholar] [CrossRef]
- European Pharmacopoeia. Methods in Pharmacognosy, 10th ed.; Council of Europe: Strasbourg, France, 2019. [Google Scholar]
- Stoicescu, I.; Lupu, E.C.; Radu, M.D.; Popescu, A.; Mihai, S. High-Performance Liquid Chromatography—Diode Array Detection (HPLC-DAD) Method for the Determination of Phenolic Compounds of Water Chestnut (Trapa natans L.). Anal. Lett 2022, 55, 2147–2159. [Google Scholar] [CrossRef]
- Crunaire, S.; Marcoux, P.R.; Ngo, K.Q.; Moy, J.P.; Mallard, F.; Tran-Thi, T.H. Discriminating Bacteria with Optical Sensors Based on Functionalized Nanoporous Xerogels. Chemosensors 2014, 2, 171–181. [Google Scholar] [CrossRef]
- Kučić Grgić, D.; Miloloža, M.; Ocelić Bulatović, V.; Ukić, Š.; Slouf, M.; Gajdosova, V. Screening the Efficacy of a Microbial Consortium of Bacteria and Fungi Isolated from Different Environmental Samples for the Degradation of LDPE/TPS Films. Separations 2023, 10, 79. [Google Scholar] [CrossRef]
- Klinker, K.P.; Hidayat, L.K.; Wenzler, E.; Balada-Llasat, J.M.; Motyl, M.; DeRyke, C.A.; Bauer, K.A. Use of Novel Antibiograms to Determine the Need for Earlier Susceptibility Testing and Administration for New β-Lactam/β-Lactamase Inhibitors in the United States. Antibiotics 2022, 11, 660. [Google Scholar] [CrossRef]
- Majeed, Z.; Qudir Javid, M.; Nawazish, S.; Ahmed, B.; Hassan Faiz, A.; Baig, A.; Baig, S.; Mahnashi, M.H.; Jalal, N.A.; Asiri, A.; et al. Clinical Prevalence, Antibiogram Profiling and Gompertz Growth Kinetics of Resistant Staphylococcus epidermidis Treated with Nanoparticles of Rosin Extracted from Pinus roxburghii. Antibiotics 2022, 11, 1270. [Google Scholar] [CrossRef]
- Khan, Z.A.; Siddiqui, M.F.; Park, S. Current and Emerging Methods of Antibiotic Susceptibility Testing. Diagnostics 2019, 9, 49. [Google Scholar] [CrossRef]
- Clinical and Laboratory Standards Institute. Performance Standards for Antimicrobial Susceptibility Testing, CLSI document M100, 30th ed.; Clinical and Laboratory Standards Institute: Wayne, PA, USA, 2020. [Google Scholar]
- AlBalawi, A.N.; Elmetwalli, A.; Baraka, D.M.; Alnagar, H.A.; Alamri, E.S.; Hassan, M.G. Chemical Constituents, Antioxidant Potential, and Antimicrobial Efficacy of Pimpinella anisum Extracts against Multidrug-Resistant Bacteria. Microorganisms 2023, 11, 1024. [Google Scholar] [CrossRef]
- Alibi, S.; Crespo, D.; Navas, J. Plant-derivatives small molecules with antibacterial activity. Antibiotics 2021, 10, 231. [Google Scholar] [CrossRef]
- Cortez Nunes, F.; Taillieu, E.; Letra Mateus, T.; Teixeira, S.; Haesebrouck, F.; Amorim, I. Molecular Detection of Metronidazole and Tetracycline Resistance Genes in Helicobacter pylori-Like Positive Gastric Samples from Pigs. Antibiotics 2023, 12, 906. [Google Scholar] [CrossRef] [PubMed]
- Wink, M. Medicinal Plants: A Source of Anti-Parasitic Secondary Metabolites. Molecules 2012, 17, 12771–12791. [Google Scholar] [CrossRef] [PubMed]
- Wang, Y.; Ma, W.; Zhou, S.; Liu, K. Lysimachia tianmaensis (Primulaceae), a new species from Anhui, China. PhytoKeys 2018, 98, 117–124. [Google Scholar] [CrossRef]
- Elshafie, H.S.; Camele, I.; Mohamed, A.A. A Comprehensive Review on the Biological, Agricultural and Pharmaceutical Properties of Secondary Metabolites Based-Plant Origin. Int. J. Mol. Sci. 2023, 24, 3266. [Google Scholar] [CrossRef] [PubMed]
- Ionus, E.; Bucur, L.A.; Lupu, C.E.; Gird, C.E. Evaluation of the chemical composition of Ajuga Chamaepitys (L.) schreb. From the spontaneous flora of Romania. Farmacia 2021, 69, 461–466. [Google Scholar] [CrossRef]
- Merlani, M.; Barbakadze, V.; Amiranashvili, L.; Gogilashvili, L.; Poroikov, V.; Petrou, A.; Sokovic, M. New caffeic acid derivatives as antimicrobial agents: Design, synthesis, evaluation and docking. Curr. Top. Med. Chem. 2019, 19, 292–304. [Google Scholar] [CrossRef] [PubMed]
- Pavlíková, N. Caffeic Acid and Diseases—Mechanisms of Action. Int. J. Mol. Sci. 2023, 24, 588. [Google Scholar] [CrossRef]
- Kępa, M.; Miklasińska-Majdanik, M.; Wojtyczka, R.D.; Idzik, D.; Korzeniowski, K.; Smoleń-Dzirba, J.; Wąsik, T.J. Antimicrobial Potential of Caffeic Acid against Staphylococcus aureus Clinical Strains. Biomed Res Int. 2018, 2018, 7413504. [Google Scholar] [CrossRef]
- Yang, S.; Lyu, X.; Zhang, J.; Shui, Y.; Yang, R.; Xu, X. The Application of Small Molecules to the Control of Typical Species Associated With Oral Infectious Diseases. Front. Cell. Infect. Microbiol. 2022, 12, 816386. [Google Scholar] [CrossRef]
- Li, Z.; Chen, K.; Peng, C.; Chi, F.; Yu, C.; Yang, Q. Antibacterial and antibiofilm activities of chlorogenic acid against Yersinia enterocolitica. Front. Microbiol. 2022, 13, 1178. [Google Scholar]
- Yadav, M.; Kaushik, M.; Roshni, R.; Reddy, P.; Mehra, N.; Jain, V.; Rana, R. Effect of Green Coffee Bean Extract on Streptococcus mutans Count: A Randomised Control Trial. J. Clin. Diagn. Res. 2017, 11, ZC68–ZC71. [Google Scholar] [CrossRef]
- Wan, F.; Zhong, R.; Wang, M.; Zhou, Y.; Chen, Y.; Yi, B.; Hou, F.; Liu, L.; Zhao, Y.; Chen, L.; et al. Caffeic Acid Supplement Alleviates Colonic Inflammation and Oxidative Stress Potentially Through Improved Gut Microbiota Community in Mice. Front Microbiol. 2021, 16, 784211. [Google Scholar] [CrossRef] [PubMed]
- Abedini, E.; Khodadadi, E.; Zeinalzadeh, E.; Moaddab, S.R.; Asgharzadeh, M.; Mehramouz, B.; Dao, S.; Samadi Kafil, H. A Comprehensive Study on the Antimicrobial Properties of Resveratrol as an Alternative Therapy. Evid. Based Complement. Alternat. Med. 2021, 16, 8866311. [Google Scholar] [CrossRef]
- Kang, J.E.; Yoo, N.; Jeon, B.J.; Kim, B.S.; Chung, E.-H. Resveratrol Oligomers, Plant-Produced Natural Products With Anti-virulence and Plant Immune-Priming Roles. Front. Plant Sci. 2022, 13, 885625. [Google Scholar] [CrossRef]
- Duke, S.O. Benefits of Resveratrol and Pterostilbene to Crops and Their Potential Nutraceutical Value to Mammals. Agriculture 2022, 12, 368. [Google Scholar] [CrossRef]
- Al Azzaz, J.; Al Tarraf, A.; Heumann, A.; Da Silva Barreira, D.; Laurent, J.; Assifaoui, A.; Rieu, A.; Guzzo, J.; Lapaquette, P. Resveratrol Favors Adhesion and Biofilm Formation of Lacticaseibacillus paracasei subsp. paracasei Strain ATCC334. Int. J. Mol. Sci. 2020, 21, 5423. [Google Scholar] [CrossRef] [PubMed]
- Hachem, C.E.; Chedid, J.C.A.; Nehme, W.; Kaloustian, M.K.; Ghosn, N.; Sahnouni, H.; Mancino, D.; Haikel, Y.; Kharouf, N. Physicochemical and Antibacterial Properties of Conventional and Two Premixed Root Canal Filling Materials in Primary Teeth. J. Funct. Biomater. 2022, 13, 177. [Google Scholar] [CrossRef] [PubMed]
- El-Telbany, M.; El-Didamony, G.; Askora, A.; Ariny, E.; Abdallah, D.; Connerton, I.F.; El-Shibiny, A. Bacteriophages to Control Multi-Drug Resistant Enterococcus faecalis Infection of Dental Root Canals. Microorganisms 2021, 9, 517. [Google Scholar] [CrossRef] [PubMed]
- Chidambar, C.K.; Shankar, S.M.; Raghu, P.; Gururaj, S.B.; Bushan, K.S. Detection of Enterococcus faecalis in subgingival biofilms of healthy, gingivitis, and chronic periodontitis subjects. J. Indian Soc. Periodontol. 2019, 23, 416–418. [Google Scholar] [CrossRef] [PubMed]
- Yildirim, A.B.; Guner, B.; Karakas, F.P.; Turker, A.U. Evaluation of antibacterial, antitumor, antioxidant activities and phenolic constituents of field-grown and in vitro-grown Lysimachia vulgaris L. Afr. J. Tradit. Complement. Altern. Med. 2017, 14, 177–187. [Google Scholar] [CrossRef] [PubMed]
Disclaimer/Publisher’s Note: The statements, opinions and data contained in all publications are solely those of the individual author(s) and contributor(s) and not of MDPI and/or the editor(s). MDPI and/or the editor(s) disclaim responsibility for any injury to people or property resulting from any ideas, methods, instructions or products referred to in the content. |
© 2023 by the authors. Licensee MDPI, Basel, Switzerland. This article is an open access article distributed under the terms and conditions of the Creative Commons Attribution (CC BY) license (https://creativecommons.org/licenses/by/4.0/).